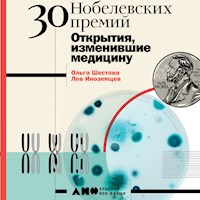
30 нобелевских премий: Открытия, изменившие медицину - Ольга Шестова - Hörbuch

Erhalten Sie Zugang zu diesem und mehr als 300000 Büchern ab EUR 5,99 monatlich.
- Herausgeber: Альпина нон-фикшн
- Kategorie: Fachliteratur
- Sprache: Russisch
Самая известная и почетная в мире премия — Нобелевская — ежегодно присуждается за выдающиеся научные исследования, революционные изобретения, вклад в культуру или развитие общества. В этой книге речь пойдет о лауреатах премии по физиологии или медицине. На момент написания книги вручено 210 премий 219 лауреатам. Из них мы отобрали 30 — тех, чьи работы широко используются, значение которых известно каждому, а суть понятна любому человеку без специального образования — небезразличному к медицине и собственному здоровью. Открытия объединены по темам и собраны в шести главах, посвященных физиологии, генетике, патогенам, медицинским методам и фармакологии. Прослушивание можно начать с любой главы — с той темы, которая вам кажется самой интересной.
Das Hörbuch können Sie hören im Abo „Legimi Premium” in Legimi-Apps auf:





























